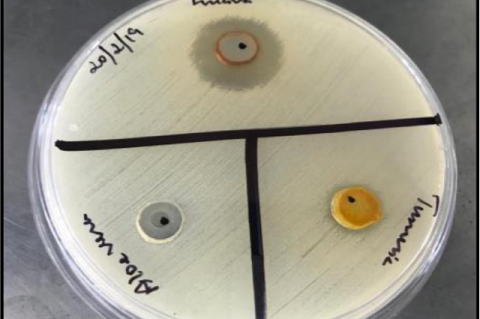
Antibacterial activity of the herbs.

Asian Journal of Biological and Life sciences, Vol 10, Issue 3, Sep-Dec, 2021
Recent Articles
Review Article
A Comprehensive Review on the Endemic Plant Docynia indica: Its Ethnobotanical, Phytochemical, and Ethnomedicinal Perspective
Joy Biswas,Pranjan Barman,Mehzabin Rahman,Rajgourab Ghosh
Asian J. Biol. Life Sci.,10(3):514-521 DOI: 10.5530/ajbls.2021.10.68 Published: Tue, 4-Jan-2022 Read More
Review Article
Caenorhabditis elegans as a Model in Studying Physiological Changes Following Heart Failure
John Sylvester Nas
Asian J. Biol. Life Sci.,10(3):522-526 DOI: 10.5530/ajbls.2021.10.69 Published: Tue, 4-Jan-2022 Read More
Review Article
Therapeutic Potential of Citrus Flavonoid Naringin in Management of Osteoporosis: Current Status and Future Perspectives
Mukesh Yadav,Nirmala Sehrawat,Sunil Kumar,Anil Kumar Sharma,Nipunjot Kaur,Amandeep Singh,Rachna Nara,Sachin Kumar
Asian J. Biol. Life Sci.,10(3):527-532 DOI: 10.5530/ajbls.2021.10.70 Published: Tue, 4-Jan-2022 Read More
Review Article
Microbial Volatile Organic Compounds: Applications and Future Prospects
Vikas Kumar,Manoj Singh,Ashwanti Devi,Kavita Rani,Amit Kumar,Sunil Kumar,Pooja Sharma,Anil K. Sharma
Asian J. Biol. Life Sci.,10(3):533-538 DOI: 10.5530/ajbls.2021.10.71 Published: Tue, 4-Jan-2022 Read More
Review Article
SNP Markers and its Impact on Crop Improvement
Debasmita Das,Rukmini Mishra
Asian J. Biol. Life Sci.,10(3):539-548 DOI: 10.5530/ajbls.2021.10.72 Published: Tue, 4-Jan-2022 Read More
Review Article
Effects of Moringa oleifera Leaf Extracts on Lipid Profile of Rats: A Meta-Analysis and Systematic Review
Laarni Hannah Lacorte,Jayson Harbey Robles,Cathleen Panganiban,John Vince Cajano,Jose Bryan Santos,Celjan Kyle Ortiz,MA Theresa Gumban,Joanne Emille Sancho,John Sylvester Nas
Asian J. Biol. Life Sci.,10(3):549-558 DOI: 10.5530/ajbls.2021.10.73 Published: Tue, 4-Jan-2022 Read More
Research Article
Extraction, Characterization and Antimicrobial Properties of Pigments from Yeast, Rhodotorula mucilaginosa Isolated from the Mangrove Sediments of North Kerala, India
Pothayi Vidya,Sreedevi Narayanan Kutty,Chempakassery Devasia Sebastian
Asian J. Biol. Life Sci.,10(3):559-565 DOI: 10.5530/ajbls.2021.10.74 Published: Tue, 4-Jan-2022 Read More
Research Article
Antioxidant Activity of Antilisterial Bacteriocns Isolated from Paenibacillus polmyxa and Enterococcus faecium GRD AA
Arya Radhakrish Krishna,Swathy Krishna Jayalekshmi,Trisha Mary Pandi Antony,Suganthi Ramasamy
Asian J. Biol. Life Sci.,10(3):566-572 DOI: 10.5530/ajbls.2021.10.75 Published: Tue, 4-Jan-2022 Read More
Research Article
In vitro Analysis of Heavy Metal Interference in Immune System of Estuarine Black Clam Villoritta cyprinoides (Gray)
Likhija Unnikrishnan,Majesh Tomson,Rajiv P,Vidhya D,Balu M. Nair
Asian J. Biol. Life Sci.,10(3):573-581 DOI: 10.5530/ajbls.2021.10.76 Published: Tue, 4-Jan-2022 Read More
Research Article
In vitro Therapeutic Effect of Spirulina Extract
Sowmya S,Suba Sri M,Dineshkumar R
Asian J. Biol. Life Sci.,10(3):582-589 DOI: 10.5530/ajbls.2021.10.77 Published: Tue, 4-Jan-2022 Read More
Research Article
Coccinia grandis Extract Exerts Antihyperglycemic Effect through its Antioxidant, α-Amylase and α-Glucosidase Inhibitory Activities: An in vitro Study
Meenatchi Packirisamy,Maneemegalai Sivaprakasam
Asian J. Biol. Life Sci.,10(3):590-596 DOI: 10.5530/ajbls.2021.10.78 Published: Tue, 4-Jan-2022 Read More
Research Article
In vitro Antioxidant, Anti-inflammatory and Antibacterial Activities of Microencapsulated Elaeocarpus tectorius (Lour.) Poir Leaf Extracts
Keerthana Manoharan,P Chitra
Asian J. Biol. Life Sci.,10(3):597-607 DOI: 10.5530/ajbls.2021.10.79 Published: Tue, 4-Jan-2022 Read More
Research Article
Formulation of Herbal Soap against Acne Causing Bacteria
Anjum Attaullah,Aruna Govindarajulu,Mohana Priya K,Mubeena KF,Sreenithi R,Summera Rafiq,Shaik Jasmine Shahina
Asian J. Biol. Life Sci.,10(3):608-613 DOI: 10.5530/ajbls.2021.10.80 Published: Tue, 4-Jan-2022 Read More
Research Article
Reproductive Toxicity Analysis of Potential Toxic Element Lead in Mice and their Regenerative Potential
Vaneet Kumar,Sandip Singh Bhatti,Sushma Sharma,Avinash Kaur Nagpal
Asian J. Biol. Life Sci.,10(3):614-619 DOI: 10.5530/ajbls.2021.10.81 Published: Tue, 4-Jan-2022 Read More
Research Article
Application of Electro- Chemical Oxidation for the Treatment of Reactive Red 195 using Graphite Electrode
Mohandas Umadevi,Ramasamy Rathinam,ThirumalaiRaj Brindha,Sivakumar Dheenadhayalan,Sangma Pattabhi
Asian J. Biol. Life Sci.,10(3):620-625 DOI: 10.5530/ajbls.2021.10.82 Published: Tue, 4-Jan-2022 Read More
Research Article
Preliminary Phytochemical Screening and GC-MS Analysis of Methanolic Extract of Roots of Pandanus fascicularis
Mary Sheeja TL,Jessy Jacob,Jaykar Balasundaram,Gomathi Venkatachalam
Asian J. Biol. Life Sci.,10(3):626-631 DOI: 10.5530/ajbls.2021.10.83 Published: Tue, 4-Jan-2022 Read More
Research Article
Evaluation of Anti-biofilm Formation of Methicillin Resistant Staphylococcus Species in Clinical Milk Samples of Bovine Mastitis using Selective Medicinal Plants
Jayaprabha Chockalingam,Akshaya Balasubramanian,Jai Santhosh K. Krishnasamy,Karthika Balasundaram,Kavin Kumar Sivasamy,Anusree Manohar,Joval Antony Mar Sagayaraj,Suganthi Ramasamy
Asian J. Biol. Life Sci.,10(3):632-641 DOI: 10.5530/ajbls.2021.10.84 Published: Tue, 4-Jan-2022 Read More
Research Article
Differential Role of cAMP, cGMP, and Ca2+ and Involvement of Kinases and CBP-CREB CRE Pathway in Regulation of Arylalkylamine N-acetyltransferase 2 mRNA Levels in the Pineal Organ of an Air-Breathing Catfish, Clarias gariepinus
Hijam Nonibala,Pynnehlang Warjri,Braj Bansh Pras Gupta
Asian J. Biol. Life Sci.,10(3):642-648 DOI: 10.5530/ajbls.2021.10.85 Published: Tue, 4-Jan-2022 Read More
Research Article
In-vitro Screening of Anti Parkinson’s Activity of Ethanolic Extract of Malaxis acuminata against Rotenone – Induced Toxicity in Sh-Sy5y Neuroblastoma Cell Lines
Gomathi Venkatachalam,Mary Sheeja T. L,Jaykar Balasundaram
Asian J. Biol. Life Sci.,10(3):649-655 DOI: 10.5530/ajbls.2021.10.86 Published: Tue, 4-Jan-2022 Read More
Research Article
Indigenous Knowledge on Medicinal Flora Utilized by the Traditional Healers in Mappillaiyurani Village, Tuticorin District, Tamil Nadu, India
Mariappan Girija,Muruganandham Priyadharshana,Veerabagu Smitha,Mariajames Arockia Badhsheeba,Vaikundaraman Vadivel
Asian J. Biol. Life Sci.,10(3):656-661 DOI: 10.5530/ajbls.2021.10.87 Published: Tue, 4-Jan-2022 Read More
Research Article
A Study on Length-Weight Relationship and Condition Factor of Three Important Freshwater Fish Species of Maijan Beel, Dibrugarh, Assam, India
Moirangthem Kameshwor Singh,Susmita Sonowal,Chandopal Saikia
Asian J. Biol. Life Sci.,10(3):662-666 DOI: 10.5530/ajbls.2021.10.88 Published: Tue, 4-Jan-2022 Read More
Research Article
Screening of Heat Stress Tolerant in Early Stage of Wheat Seedling using Morphological Parameters
Pooja Sharma,Raj Singh,Monika Dahiya,Vikas Kumar,Amit Kumar,Anil Kumar Sharma
Asian J. Biol. Life Sci.,10(3):667-672 DOI: 10.5530/ajbls.2021.10.89 Published: Tue, 4-Jan-2022 Read More
Research Article
Qualitative Method of Salmonella Screening, Identification and Confirmation in Shrimp Matrices using Loop-mediated Isothermal Amplification Method, Enzyme Linked Immuno Fluorescent Assay and Standard Conventional Method
Anikkadan Shimna,Tresa Levina
Asian J. Biol. Life Sci.,10(3):673-680 DOI: 10.5530/ajbls.2021.10.90 Published: Tue, 4-Jan-2022 Read More
Research Article
Gibberellic and Indole Acetic Acids Producing Features of Bacteria from the Genus Lactobacillus and their Effect on Plant Development
Bakhora Ismoilovna Turaeva,Kamolova Khulkar Fo qizi,Azamjon Bakhodirov Soliev,Guzal Jumaniyazo Kutlieva
Asian J. Biol. Life Sci.,10(3):681-686 DOI: 10.5530/ajbls.2021.10.91 Published: Tue, 4-Jan-2022 Read More
Research Article